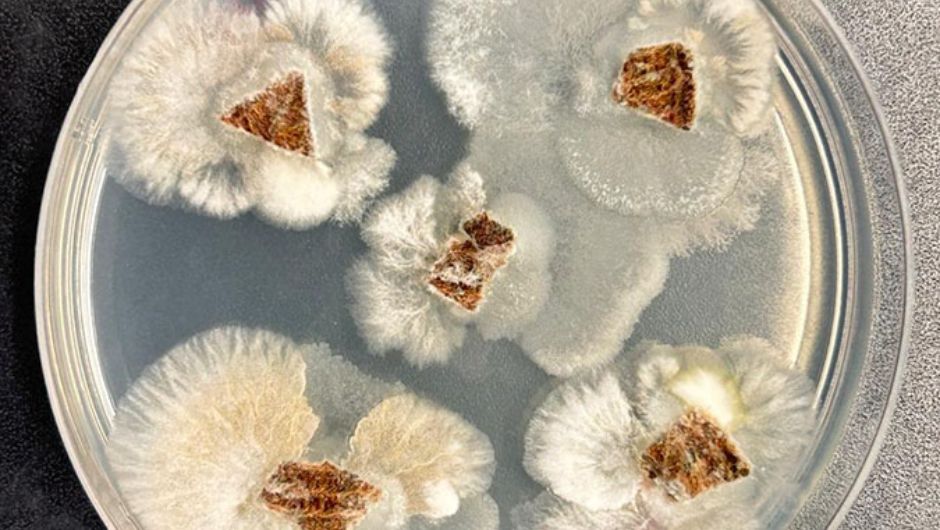
Fungos endofíticos saindo de dentro do tecido foliar
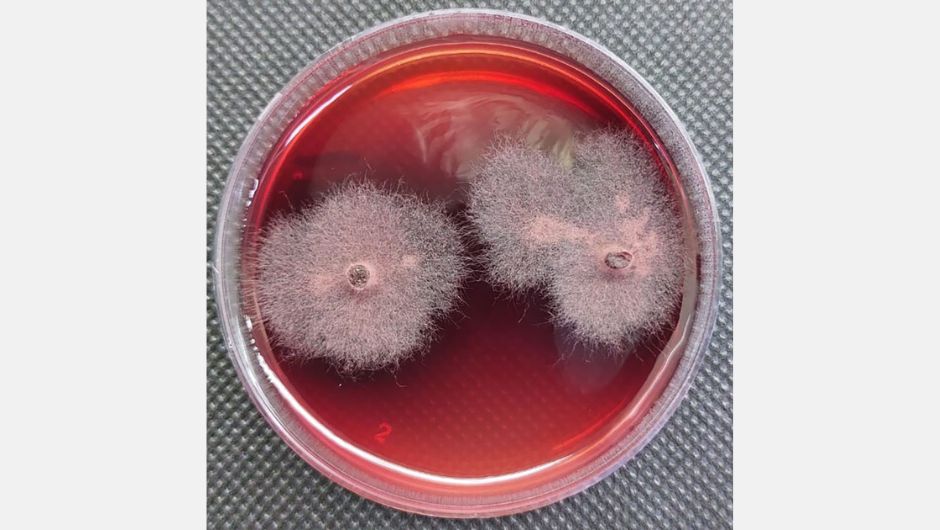
Fungos endofíticos

New Holland amplia portfólio para vinhedos estreitos
Nova colhedora 9.80N apresenta uma cabine aprimorada com maior conforto para o operador

Pesquisadores da Universidade Federal de Minas Gerais (UFMG), da Embrapa Meio Ambiente e do Departamento de Agricultura dos Estados Unidos (USDA) identificaram uma substância inédita na literatura científica com forte potencial herbicida e antifúngico. O composto foi extraído de um fungo endofítico isolado de uma planta medicinal tropical do gênero Piper e apresentou desempenho comparável — e em alguns casos superior — ao de pesticidas sintéticos já consolidados no mercado.
A descoberta amplia o repertório de moléculas naturais que podem servir de base para o desenvolvimento de bioinsumos, segmento estratégico diante da crescente busca por alternativas sustentáveis ao uso de agroquímicos convencionais.
O fungo estudado, identificado como Fusarium sp. UFMGCB 15449, produziu três metabólitos bioativos: anidrofusarubina, javanicina e um terceiro composto até então desconhecido, apelidado pelos cientistas como “composto 2” (5,10-di-hidroxi-1,7-dimetoxi-3-metil-1H-benzo[g]isocromeno-6,9-diona). Foi este último que se destacou por sua forte ação fitotóxica e antifúngica.
Segundo Luiz Henrique Rosa, professor da UFMG, o resultado reforça o potencial de fungos endofíticos como fonte de novas moléculas bioativas. “Esses microrganismos são reservatórios ainda pouco explorados. Cada nova espécie estudada pode revelar compostos promissores para aplicações agrícolas”, afirma.
Nos testes conduzidos em sementes de alface (Lactuca sativa) e grama-de-bent (Agrostis stolonifera), modelos amplamente usados na triagem de herbicidas, todos os compostos isolados inibiram totalmente a germinação das plantas na concentração de 1 mg/mL. O desempenho foi semelhante ao do acifluorfeno, herbicida sintético utilizado como referência.
Ensaios com lentilha-d’água (Lemna), espécie usada para avaliar toxicidade ambiental, reforçaram os resultados: os metabólitos apresentaram valores de IC50 inferiores aos de glifosato e clomazona, dois dos herbicidas mais utilizados no mundo.
Na frente antifúngica, o composto 2 também se destacou contra Colletotrichum fragariae, patógeno de importância agrícola, exibindo zonas de inibição maiores que as geradas por carvacrol e timol, amplamente utilizados como fungicidas naturais.
Para Sonia Queiroz, pesquisadora da Embrapa Meio Ambiente, os resultados são animadores. “Existe um espaço crescente para soluções biológicas capazes de reduzir impactos ambientais sem comprometer a eficiência no controle de pragas e doenças”, afirma.

O Fusarium sp. UFMGCB 15449 foi coletado no Parque Estadual da Floresta do Rio Doce (MG) e preservado na coleção de micro-organismos da UFMG. A identificação envolveu análises de DNA e comparação com sequências do GenBank. A confirmação do gênero foi possível, mas a determinação da espécie esbarrou na complexidade taxonômica do grupo — algo comum em Fusarium, que concentra dezenas de espécies muito próximas entre si.
Os pesquisadores destacam que o estudo reforça a importância da conservação dos biomas brasileiros, que abrigam um patrimônio genético ainda pouco explorado. “Florestas e matas nativas podem guardar organismos com potencial para revolucionar áreas como agricultura e saúde”, afirma Rosa.
O trabalho também avança na direção de novas estratégias para enfrentar um dos maiores desafios da agricultura global: o aumento da resistência de pragas e patógenos aos defensivos químicos tradicionais.
A equipe agora planeja investigar os mecanismos de ação dos compostos, avaliar sua segurança ambiental e explorar possíveis modificações estruturais para aprimorar eficácia e estabilidade. Ensaios em condições de campo e o estudo do efeito hormético — observado quando baixas doses estimularam o crescimento vegetal — também estão no horizonte.
“Estamos abrindo uma nova fronteira científica”, resume o grupo. “Microrganismos invisíveis podem se tornar aliados estratégicos na transição para uma agricultura mais sustentável”, concluem os autores.
Mais informações podem ser obtidas em: https://doi.org/10.1590/0001-3765202520241059

Receba por e-mail as últimas notícias sobre agricultura